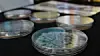

Forskningsfest
Det myldrer av barn på Universitetsplassen, jazzbandet svinger, Fabian Stang tar high-fives med de elleville barna, og Kristin Halvorsen smiler tross nederlaget forrige mandag. Forskningsdagene er i gang.

Forskning forbindes ofte med tall, formler og eldre menn med langt bustete skjegg.
Forskningsdagene ønsker å bevise at det er mye mer: Forskning er gøy!
Universitetsplassen fylles derfor hvert år av gira forskere som er ute etter å inspirere. Blant disse er Universitetet i Oslo (UiO), Høgskolen i Oslo og Akershus (HiOA), BI og Veterinærhøgskolen (NVH) representert.
Brenner for fisk
Svein Jakob Saltveit, forsker ved Naturhistorisk Museum (NHM), er en av de som brenner for faget. På NHMs stand viser de fram dyr som finnes i vann og viktige organismer for fisk.
– Vi ønsker å fortelle de som bor i Oslo om at de må være varsomme med utslipp, sier han til Universitas.
De har også et par døde fisker liggende for å demonstrere hvordan de undersøker fisken, til publikums store forferdelse. Saltveit forklarer med overstrømmende entusiasme om den utrydningstruede elvemuslingens livssyklus, en art som kan bli hele 300 år gammel.
NHM mener det er viktig å vise hvordan inngrep i naturen påvirker vassdragene, og ønsker å motivere dagens unge til å bli biologer.
– Vi begynner å bli gamle, og de unge bør få en annen interesse enn data og økonomi, sier Saltveit.
Kreativitetstest og kosebamser
Det er dårlig med fisk på standen til BI, men til gjengjeld kan du teste kreativiteten din.
– Vi har utarbeidet kjennetegn for kreativitet, og teknikker som gjør at du kan bli mer kreativ, forklarer Audun Farbrot, fagsjef for forskningskommunikasjonen på BI.
Videre forteller han, med et smil om munnen, at de ikke har forsøk som lukter, smeller, smaker eller dufter, men de lar deg bli bedre kjent med deg selv. Det er bra, hevder de, både for en selv og for arbeidslivet.
På standen til Veterinærhøgskolen (NVH) tar de blodprøver på kosedyr.
Publikum kan selv prøve seg som blodprøvetaker på lille Fido. Studentene tror det vil trekke folk.
Erik Paulshus, student ved Veterinærhøgskolen, forklarer Universitas at de ønsker å inspirere folk til å bli interessert i veterinærmedisin. Medstudentene, Kristin Bjørklund, Mari Viken og Marie Myklatun Krosness nikker alle anerkjennende, og påpeker at det foregår mye forskning på NVH.
– Vi har til og med en sebrafisk-lab på skolen, forteller studentene ivrig, og det blir raskt tydelig hvorfor disse studentene representerer skolen.
Mugg og sopp
Ved Høgskolen i Oslo og Akershus Høgskolen (HiOA) sin bod er det gjenklang av «æsj» og «hva ER det?». Boden er nemlig full av mugg og sopp, heldigvis forsvarlig innpakket.
Forferdelsen blant de unge forskerspirene blir ikke mindre når Christian Pedersen, ingeniørstudent i energi og miljø i bygg, forteller barna at dette er sopp som er ute i lufta og inne i klasserom.
Det er første gang Pedersen står på stand, og han trives godt med å bringe HiOAs forskningsresultater ut til barna.
– Vi viser de beste sidene ved det å være ingeniør.
– Vi viser de beste sidene ved det å være ingeniør, sier han med et smil, før ivrige skolebarn og potensielle ingeniørstudenter kaller.

































